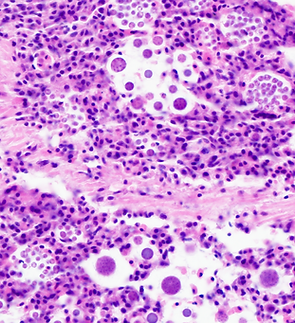
6789 2 QPX heart 40x.tif

top of page
Our Services
The Aquatic Diagnostic Laboratory offers many different types of diagnostic assays for aquatic organisms, specializing in shellfish and finfish diseases.
We provide disease testing for all life stages, larvae to adult. The type of testing needed is dependent on the host species and pathogens of concern. Please see the descriptions of the diagnostic services offered and submission instructions.
Get a Quote
For diagnostics not included in the above price lists, please contact us for a tailored quote.
bottom of page